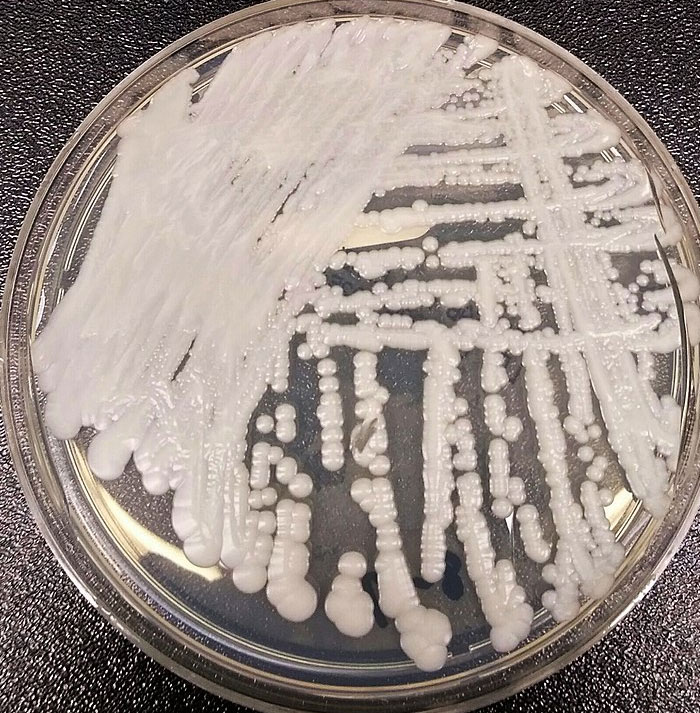
39 People Predict Potential Disasters That Most Of The World Are Clueless About

No one knows what the future holds. However, specific indicators may serve as omens for potentially disastrous events, and these signs may be noticeable for some.
Those people took time to answer this serious Reddit question: “What’s a disaster that is very likely to happen but not many people know about?” One person predicted the possible collapse of ocean fisheries. Another foresaw an alarming decline of pollinator insects like bees and how it may affect the world’s ecosystems and biodiversity.
None of these folks provided their sources or where they got their information, but if you’re a fan of doomscrolling, you may enjoy this list.

This post may include affiliate links.
 Happens every election in the USA, the sheeple are encouraged to get at each others throats supporting a couple of personalities, whilst they continue to be hoodwinked by the corporations and lobby groups who drive America.
Happens every election in the USA, the sheeple are encouraged to get at each others throats supporting a couple of personalities, whilst they continue to be hoodwinked by the corporations and lobby groups who drive America.
* No free healthcare at point of contact
* Longer working hours than any country in Europe
* Less vacation that almost every country in the world
* C**p food loaded with sugar and chemicals
* Communities set up for cars, not people.
 An often overlooked disaster is the rapid decline of insects, especially pollinators such as bees. Although bee extinction is not immediate, it could have a significant impact on global food resources, ecosystems and biodiversity. Without these pollinators, many crops would fail, leading to food shortages and economic disruption. But this important issue has not received enough attention.
An often overlooked disaster is the rapid decline of insects, especially pollinators such as bees. Although bee extinction is not immediate, it could have a significant impact on global food resources, ecosystems and biodiversity. Without these pollinators, many crops would fail, leading to food shortages and economic disruption. But this important issue has not received enough attention.
Care for all bees, not just honey bees. I would say all species of solitary bees are way more important than honey bees! And there are plenty of honey bees, they just needs to be treated bee-ely 🙃. But instead make nesting for solitary bees!
 As far as global pandemics go, COVID was not nearly as devastating as it could have been. Keep all aspects of COVID the same, but increase its lethality. For context, the bubonic plague killed ~80% of those who became infected.
As far as global pandemics go, COVID was not nearly as devastating as it could have been. Keep all aspects of COVID the same, but increase its lethality. For context, the bubonic plague killed ~80% of those who became infected.
If something with the same transmitability and lethality as the bubonic plague manifested today...especially now that we've seen how people respond to pandemic controls...we'd be finished.
The next pandemic is gonna be a s.hit show regardless of its lethality because the covid deniers will multiply with the covid survivors and claim its all bogus and we didn't die last time but we suffered for no reason blah, blah, blah. I can't see the world cooperating a second time as it did for covid and that is terrifying.
 The ocean fisheries will collapse. Yesterday's trash species are today's featured "catch of the day", will be tomorrow's memory. Harvesting is occurring at unsustainable rates while environmental degradation is steadily reducing habitat and forage ranges.
The ocean fisheries will collapse. Yesterday's trash species are today's featured "catch of the day", will be tomorrow's memory. Harvesting is occurring at unsustainable rates while environmental degradation is steadily reducing habitat and forage ranges.
For many people in developed nations, fish is one option, among many, for protein. For most people in developing nations, it is the cheapest and most accessible option. When it's gone, there will be catastrophic sociopolitical and economic upheavals.
 Microplastics. Its being found everywhere in our environment and is already being discovered in the blood/tissues of wildlife and humans. Scientists dont even know what the long term health effects of this will be. I am betting on it being nothing good.
Microplastics. Its being found everywhere in our environment and is already being discovered in the blood/tissues of wildlife and humans. Scientists dont even know what the long term health effects of this will be. I am betting on it being nothing good.
Not just the "raw" plastics, but the additives that are added to give the plastic different properties?
 Deep fakes. You may think you can tell the difference now, but as it gets more sophisticated you're not going to be any better at identifying it than your grandparents. What will the world be like when we can't trust anything we see or hear? What will happen when anyone can make a video of you saying anything they want or deny the terrible things they are doing by simply saying it is a seek fake of them? I sincerely believe the consequences will be the end of humanity as we know it.
Deep fakes. You may think you can tell the difference now, but as it gets more sophisticated you're not going to be any better at identifying it than your grandparents. What will the world be like when we can't trust anything we see or hear? What will happen when anyone can make a video of you saying anything they want or deny the terrible things they are doing by simply saying it is a seek fake of them? I sincerely believe the consequences will be the end of humanity as we know it.
 The amount of methane and other gases that are bubbling up from the arctic is alot more than previously thought. Greenhouse gases on steroids.
The amount of methane and other gases that are bubbling up from the arctic is alot more than previously thought. Greenhouse gases on steroids.
 AMOC (Atlantic Meridional Overturning Circulation) slowing/ halting. Melting of northern latitude glaciers are effectively hosing the North Atlantic Ocean with cold fresh water, disrupting the global conveyor belt in the ocean which redistributes heat across the planet. If AMOC slows enough (which we’re looking at happening within decades, not centuries) global weather patterns will shift entirely, Western Europe will freeze, the southern hemisphere will retain much more heat, sea level rise will increase significantly, the oceans will lose some of their capacity to sequester CO2 which in turn increases atmospheric warming, melting of glaciers, etc. generating a positive feedback loop
AMOC (Atlantic Meridional Overturning Circulation) slowing/ halting. Melting of northern latitude glaciers are effectively hosing the North Atlantic Ocean with cold fresh water, disrupting the global conveyor belt in the ocean which redistributes heat across the planet. If AMOC slows enough (which we’re looking at happening within decades, not centuries) global weather patterns will shift entirely, Western Europe will freeze, the southern hemisphere will retain much more heat, sea level rise will increase significantly, the oceans will lose some of their capacity to sequester CO2 which in turn increases atmospheric warming, melting of glaciers, etc. generating a positive feedback loop
We really don’t want AMOC to stop lol.
 Antibiotic resistance and the emergence not only of super bugs, but pan d**g resistant bacteria. Reports say that by year 2050, deaths by infections caused by super bugs will be one of the leading causes of mortality.
Antibiotic resistance and the emergence not only of super bugs, but pan d**g resistant bacteria. Reports say that by year 2050, deaths by infections caused by super bugs will be one of the leading causes of mortality.
Regrettably, bacteria are evolving faster than we can develop new antibiotics, and the indiscriminate use of antibiotics in the dairy and poultry industries is only worsening the situation.
Perhaps not as big as a natural disaster, but horrifying nonetheless.
ETA: this kind of blew up before I noticed. I wish to correct myself, as some people have pointed out, the real issue is the speed at which we are developing new antibiotics and the willingness to develop them, other d***s are more profitable (e.g. chemotherapy), let us hope that new development in phage therapies or new antibiotics will be available before it is too late.
This is something scientists have talked about for decades! Pharmaceuticals aren't interested because no big money to make out of finding new antibiotics! Discover Magazine had many articles about this 20-30 years ago, and now we are seeing the results of this policy with the d**g companies.
 It's been written about but no one I speak to, even in my hospital, realize it. A very worrying doctor shortage. Not only were there simply more boomers, but they're also aging out and will now need more intensive medical care.
It's been written about but no one I speak to, even in my hospital, realize it. A very worrying doctor shortage. Not only were there simply more boomers, but they're also aging out and will now need more intensive medical care.
In the US, about 10% of medical school graduates are unable to get into a residency program.
 Most people don’t realize how fragile the US (and I’m guessing other countries) food systems are. There are very few smaller family farms, everything is corporate owned. If anything disrupts the distribution channels (a truckers strike, warehouse house strike) most super markets will be put of fresh food in 3-4 days. And when that starts the panic of buying canned food will clear the rest.
Most people don’t realize how fragile the US (and I’m guessing other countries) food systems are. There are very few smaller family farms, everything is corporate owned. If anything disrupts the distribution channels (a truckers strike, warehouse house strike) most super markets will be put of fresh food in 3-4 days. And when that starts the panic of buying canned food will clear the rest.
Not a doomsday guy, but you can fit a lot of staple foods under your bed if you don’t have pantry space.
More terrifying to me is the proposal, thankfully rejected, of having meat processors "self certify" ie: removing USDA oversight. You hear the conservative whine of Government over reach? THAT's what they're talking about. The fact of the recent Boars Head recall should remove any doubt about USDA's value.
 Most large scaling farming practices are non renewable. Like we need to continuously find new ways to farm things or we won’t be able to grow food anywhere near the scale we do now.
Most large scaling farming practices are non renewable. Like we need to continuously find new ways to farm things or we won’t be able to grow food anywhere near the scale we do now.
In rural Michigan, our farmers are using 'no till' much more than they have. Less fuel used, less erosion, less waste.
 The over abundance of doomscrolling / posting doomscrolling content and how it wears on people’s psyche negatively to the point where it feels inescapable and utterly trapped from the crippling weight of the world.
The over abundance of doomscrolling / posting doomscrolling content and how it wears on people’s psyche negatively to the point where it feels inescapable and utterly trapped from the crippling weight of the world.
Meanwhile, outside, animals don’t know what day of the week it is but they’re happy to be here for the most part.
Let’s all [Seriously] let up.
 I’ve worked with water for the majority of my professional career.
I’ve worked with water for the majority of my professional career.
If the average American had any idea how uneducated and stupid your average water operator is…
The disaster is already happening. Water and wastewater districts all over the country are lying about what’s in the products coming out of their plants.
I dont believe they should be referred to as "stupid.'' Un-trained, under-trained, un/under-educated, yes. But let's not stoop to insults.
 The Cascadia Subduction Zone off the coast of the Pacific Northwest will rip again. Depending on the specifics, it will be a really bad day, or an utterly catastrophic day, for the PNW. That will be from the earthquake itself and from the subsequent tsunami. It rips every several hundred years and the last one was in the year 1700. [Here’s an article about it.](https://www.newyorker.com/magazine/2015/07/20/the-really-big-one).
The Cascadia Subduction Zone off the coast of the Pacific Northwest will rip again. Depending on the specifics, it will be a really bad day, or an utterly catastrophic day, for the PNW. That will be from the earthquake itself and from the subsequent tsunami. It rips every several hundred years and the last one was in the year 1700. [Here’s an article about it.](https://www.newyorker.com/magazine/2015/07/20/the-really-big-one).
Living in Japan, earthquakes were almost a daily thing with very small ones…. When the pressure is constantly relieved it seems like it’s safer. ….But when the subduction zone goes sproing on the eastern Pacific side, it will cause a tsunami that will scour a lot of the coast off the map. …..Seaside Oregon moved their school after a lot of research by the community, who was reluctant, but put it up on the hillside east of town. ….there is so little concern for tsunamis compared to Japan. …We are due. But I just read a Science article that maybe there is a kind of easing of the pressure that prevents it…..during Nisqually (20 miles deep and only 6.8) we got a wake up call…..more info … https://www.science.org/doi/10.1126/sciadv.add6688
 Our carbon sink has been diminishing year after year and it's getting to the point where we are not really filtering much of the carbon out anymore and desperately need to seek out new solutions such as using large algae ponds and so on
Our carbon sink has been diminishing year after year and it's getting to the point where we are not really filtering much of the carbon out anymore and desperately need to seek out new solutions such as using large algae ponds and so on
No the solution is not just planting trees everywhere, trees are actually relatively inefficient at filtering air and focus needs to be on things such as seeding local ponds and lakes with local algae blooms and other much more efficient and easier to upkeep methods of producing large amounts of air filtering plants.
 Yellowstone is an actual super volcano that has blown up every 650,000 years or so.
Yellowstone is an actual super volcano that has blown up every 650,000 years or so.
That’s why it has so many hot springs and geysers… there’s f*****g lava underneath it.
Its caldera is centered under the lake.
The lake has been getting warmer, and the center of it has risen a little bit.
If I recall correctly, it’s been about 650,000 years since the last time it blew up.
I don’t know how “likely” it is in our lifetime but the Yellowstone supervolcano will, eventually, blow.
 There is going to be a serious disaster when you get very high humidity and temperature, it's called a wet bulb event.
There is going to be a serious disaster when you get very high humidity and temperature, it's called a wet bulb event.
Death rates in that city will be very high and if it hits Mecca during the Hajj the death rate will be astronomical.
Dry areas of the world are creating artificial humidity with irrigation, swimming pools, swamp coolers, etc. The old joke “but it’s a dry heat” doesn’t really apply anymore.
 Solar flare-induced blackout. A massive solar storm could fry electrical grids and satellites, causing a global communications and power blackout.
Solar flare-induced blackout. A massive solar storm could fry electrical grids and satellites, causing a global communications and power blackout.
They know when they're coming and can turn s**t off, the last one was so massive you could see the aurora angel in well lit areas, no damage was caused.
 Human medication / illicit substances are flowing into water systems via sewage and becoming a real threat to our wildlife.
Human medication / illicit substances are flowing into water systems via sewage and becoming a real threat to our wildlife.
They need to start cleaning the water from any form of drŭgs or natural hormones etc!
 A major fissure eruption in SE Iceland.
A major fissure eruption in SE Iceland.
Since the Norse Settlement there have been two - the Eldgjá eruption c939 CE and the Lakagigur eruption of 1783-4. Although Eldgjá was larger, the massive Laki eruption is better documented. It created local devastation, crop failures, poisoned grazing animals and people. Half of the farm animals and twenty percentage of Icelanders died. Things got so bad that the Danish government considered evacuating the entire island.
We now know the Laki plume of sulfur dioxide spread across the Northern Hemisphere. In the UK, it killed tens of thousands of people; elsewhere there were crop failures and poisonous fogs. The climate went berserk with a series of bitterly cold winters that caused the Mississippi to freeze in New Orleans and ice floes in the Gulf of Mexico. Rains in the Nile Valley and the monsoon in India and China failed leading to famine. Total death toll in the 18th Century - anything up to 1 million people.
[EDIT] Thanks for all the upvotes folks - I didn't expect that to blow up (ahem) for something I wrote waiting for the kettle to boil.
If people want to know more - some resources you might find useful.
1) The Wikipedia page on Laki is pretty awesome and goes into much more detail than I could here.
2) If you want a contemporary report of the eruptions, you can't do better than Jón Stengrimsson's 'Fires of the Earth' written when he was parish priest in the area during the disaster. There is an English translation published by the University of Iceland, but it is somewhat hard to find. It is awesome.
3) Yes, you can visit Laki - although it is not especially impressive at ground level. The craters formed in the eruption are a 25km chain not far from Kirkjubæjarklaustur in SE Iceland (don't try pronouncing it unless you are Icelandic). They are off the main road on routes F206 (Lakavegur) and F207 (Lakagigavegur). These are dirt tracks, really only suited for four wheel drive and in summertime. You can't do it as a day trip from Reykjavík, but there is plenty to see and do in the area.
4) If you want the best scientific paper about the effects of Laki, then I would recommend Steven Self and Thorvaldur Thordarson's 'Atmospheric and environmental effects of the 1783–1784 Laki eruption: A review and reassessment'
https://agupubs.onlinelibrary.wiley.com/doi/full/10.1029/2001jd002042
5) Another scientific paper worth looking at - if you can get access is 'Illness and elevated human mortality in Europe coincident with the Laki Fissure eruption' by J. Grattan , M. Durand and S. Taylor which includes data from English burial records which was some of the first evidence that the eruption poisoned people outside of Iceland.
Sounds like this would be considered an E.L.E.= Extinction Level Event
 Epochalypse
Epochalypse
In 2038, the old Unix/Linux systems that have physical 32 bit time registers are going to “run out of time”. Kind of like the Y2K bug but this is a physical memory issue.
Hopefully all the old systems will be swapped out by then.
Some dudes "but nothing happened with the Y2K-bug, so why bother?!" Nothing happened, because of they had time to fix it! And the same with the ozon hole, they banned freons and s**t, and the hole is recovering.. 👍
The true disease scare is in fungal infections as they are becoming harder and harder to catch, easier to misdiagnose and there are some fungal infections spreading right now that can live on surfaces for months be misidnefied easily and are not susceptible to most anti fungal. Look up candida auris.
The true disease scare is in fungal infections as they are becoming harder and harder to catch, easier to misdiagnose and there are some fungal infections spreading right now that can live on surfaces for months be misidnefied easily and are not susceptible to most anti fungal. Look up candida auris.
 Nuclear escalation in Ukraine/Russia.
Nuclear escalation in Ukraine/Russia.
Or a terrorist organization getting their hands on a nuke.
All it takes is one.
The now fairly obscure George Clooney/Nicole Kidman 1997 film the peacemaker has a horrifying line that still applies even more today than it did at the time: “ I don’t fear the person storing multiple nuclear weapons. I’m terrified of the person who only wants one.”
 People don't really know but coffee beans are on their way to extinction.
People don't really know but coffee beans are on their way to extinction.
[https://www.smithsonianmag.com/smart-news/more-half-all-coffee-species-are-risk-extinction-180971289/](https://www.smithsonianmag.com/smart-news/more-half-all-coffee-species-are-risk-extinction-180971289/)
[https://www.kew.org/about-us/press-media/kew-scientists-reveal-that-60-of-wild-coffee](https://www.kew.org/about-us/press-media/kew-scientists-reveal-that-60-of-wild-coffee)
[https://www.weforum.org/agenda/2019/02/many-coffee-species-threatened-with-extinction/](https://www.weforum.org/agenda/2019/02/many-coffee-species-threatened-with-extinction/).
 A prion disease outbreak. There would be little we could do besides try to quarantine everyone who’s affected. If people don’t show symptoms quickly, then that may not be effective. There would be no treating anyone who was affected, destruction through cremation is about all you can do to a prion.
A prion disease outbreak. There would be little we could do besides try to quarantine everyone who’s affected. If people don’t show symptoms quickly, then that may not be effective. There would be no treating anyone who was affected, destruction through cremation is about all you can do to a prion.
Example being chronic wasting disease in ruminants. Deer, cattle, goats, etc. It's here already.
 Bacteria will become resistant to our antibiotics.
Bacteria will become resistant to our antibiotics.
Things contributing to that are countries where they are over the counter, use in animals, s****y substandard d***s manufactured in developing countries with inadequate levels of the d**g, prescriptions of antibiotics for colds or flu.
As noted above(#16) once the Z-pak loses effectiveness, it ain't gonna be good.
 A powerful earthquake along the New Madrid Fault in Missouri. .
A powerful earthquake along the New Madrid Fault in Missouri. .
The last time the New Madrid fault let go in the early 19th century, the population was low, and there was virtually no infrastructure. Now the area is heavily populated and is filled with roads, rail lines and cities that are not even close to being earthquake proof. The cost to the national economy when it lets go again will be devastating.
 China invading Taiwan and a major semiconductor shortage would pretty much bring so many things to a halt.
China invading Taiwan and a major semiconductor shortage would pretty much bring so many things to a halt.
 The global water scarcity crisis. While climate change, natural disasters, and other environmental issues are often in the spotlight, the looming shortage of freshwater resources poses a massive threat to billions of people in the near future.
The global water scarcity crisis. While climate change, natural disasters, and other environmental issues are often in the spotlight, the looming shortage of freshwater resources poses a massive threat to billions of people in the near future.
Why Water Scarcity is a Major Threat:
Rapid Population Growth: As the global population increases, the demand for water grows. Agriculture, industry, and household needs all rely heavily on freshwater, and we’re using it faster than it’s being replenished in many regions.
Overuse of Groundwater: Many areas, especially in heavily agricultural or industrialized regions, are over-extracting groundwater from aquifers that take decades or centuries to recharge. This overuse can lead to water shortages, sinking ground (land subsidence), and even the collapse of local ecosystems.
Climate Change: Changes in rainfall patterns and increased droughts, exacerbated by global warming, are making freshwater less predictable and less available. Some regions that rely on glaciers or snowmelt for water, like parts of South Asia, could face severe shortages as these ice reserves shrink.
Water Pollution: Industrial waste, agricultural runoff, and untreated sewage are contaminating many freshwater sources, making them unusable or unsafe without costly treatment. The growing pollution of rivers, lakes, and groundwater further shrinks the available supply of drinkable water.
 A solar storm.
A solar storm.
It basically occurs when the sun ejects a massive burst of solar wind and magnetic fields into space. When these reach earth, they can interact with our plant’s magnetic field, creating geomagnetic storms.
One historical precedent would be The Carrington Event of 1859, it’s the most “famous” one. It caused widespread telegraph outages and even fires. At the time, electrical infrastructure was minimal.
If a similar event happened today, the impact would be far greater due to our reliance on modern technology.
It’s likely because solar storms are a natural part of the sun’s cycle, with the sun going through peaks of activity (solar maximums) roughly every 11 years. NASA and other space agencies actively monitor space weather, but the general public is largely unaware of its existence or the risks
The Carrington Event was rare but statistically we may expect similar occurrences once every 100-200 years. Given the Carrington Event was around 150 years ago, we can expect another one “soon” based on these facts.
There's so much hatred on this site for all things American, but this is one issue where America is really backward: Most of our electrical infrastructure is exposed. You walk through an American town, and there's the electrical infrastructure, just hanging in the breeze, like it's pre-WW2 (because WW2 happened "over there").
 We're running out of the mineral that curling stones are made out of. Eventually we won't be able to enjoy curling at all in it's current form. The winter Olympics will never be the same.
We're running out of the mineral that curling stones are made out of. Eventually we won't be able to enjoy curling at all in it's current form. The winter Olympics will never be the same.
So people won't be pushing a rock around an ice rink with a glorified Swiffer. I think I'll survive this "catastrophy"
Historically, bird flu has a [52% death rate in humans](https://www.yalemedicine.org/news/h5n1-bird-flu-what-to-know).
A huge avian flu outbreak in cows started in Texas earlier this year, and is currently spreading across California.
[https://www.latimes.com/environment/story/2024-10-20/as-bird-flu-outbreaks-rise-piles-of-dead-cows-become-morbid-central-valley-tableau](https://www.latimes.com/environment/story/2024-10-20/as-bird-flu-outbreaks-rise-piles-of-dead-cows-become-morbid-central-valley-tableau)
UC Davis: [1 in 5 milk samples from grocery stores test positive for bird flu](https://health.ucdavis.edu/news/headlines/grocery-store-milk-tests-positive-for-bird-flu-why-the-fda-says-its-still-safe-to-drink/2024/04) — but it's safe because of pasteurization. (Let's not talk about raw milk which is not pasteurized.)
If you want a real life conspiracy:
Inside the Bungled Bird Flu Response, Where Profits Collide With Public Health
[https://www.vanityfair.com/news/story/inside-the-bungled-bird-flu-response](https://www.vanityfair.com/news/story/inside-the-bungled-bird-flu-response)
Some quotes from that story:
* "Since the H5N1 bird flu virus was first reported in California in early August, 124 dairy herds and 13 people — all dairy workers — have been infected."
* “The majority of dairy workers in California have no protections. Most of them are immigrants. And I would say at least half of them are undocumented,” ... “These are folks that don’t have a particular relationship of trust with state and federal government officials.”
* “A lot of people have it,” said a woman working behind the cash register at Tipton’s Dollar General, one of the few stores in this small, agricultural community right off of Highway 99.
The biggest fear is that all those people who have it in the community then get another flu and then they breed a new avian flu variant that is super transmissible in humans, which then comes with the 52% death rate.
For context, COVID's death rate was about 2.1 to 2.3%.
Avian flu subreddit: r/H5N1_AvianFlu.
Leaving out the part where some people were specifically looking for the flu infected raw milk. The CDC was saying not to drink it, you wouldn't get the flu but it was still causing death at a pretty high click. Their conspiracy riddled minds thought that if the CDC is saying not to drink it, I must do the opposite because the guvmint lies about everything
 We will have quantum computers. When that happens there is going to be massive implications given that it cracks modern encryption. Even if we move to encryption that isn't crackable by quantum computers, all the data that existed prior will be able to be unencrypted so all the current data that governments and bad actors have squirreled away and stored, waiting to be able to mass decrypt it, will be available to them.
We will have quantum computers. When that happens there is going to be massive implications given that it cracks modern encryption. Even if we move to encryption that isn't crackable by quantum computers, all the data that existed prior will be able to be unencrypted so all the current data that governments and bad actors have squirreled away and stored, waiting to be able to mass decrypt it, will be available to them.
 "The Big One" in northern Utah. We live on/near a fault line that rarely produces earthquakes. A 5.4 with a ton of aftershocks happened, so some awareness has been raised, but there's countless buildings/structures in Salt Lake County *alone* that will collapse in an earthquake.
"The Big One" in northern Utah. We live on/near a fault line that rarely produces earthquakes. A 5.4 with a ton of aftershocks happened, so some awareness has been raised, but there's countless buildings/structures in Salt Lake County *alone* that will collapse in an earthquake.
Utah/S Idaho is a bit better prepared than Missouri and its New Madrid Fault, and with much better food storage.
I'm not sure if this counts as a disaster? Folks have known for a while that in the coming decades Florida's municipal fresh water infrastructure will fail due to [salt water intrusion](https://www.floridamuseum.ufl.edu/earth-systems/blog/tell-me-about-saltwater-intrusion-in-florida/). It's already started in certain places and large metros like [Miami are trying to curb it](https://www.miamidade.gov/global/water/conservation/saltwater-intrusion.page).
Tl;dr the bedrock under Flordia is porous. Salt water gets into it from below; fresh water fills it from above. Sea levels are rising; salt water is pushing up harder. The freshwater on the surface can't get to the bedrock (both from active drainage and ability of water to reach the rock blocked by asphalt, buildings, etc); the freshwater is pushing down weaker. This moves the level where freshwater turns into salt water higher up in the bedrock.......where all the current plumbing water inputs are....
We left Florida 14 years ago because of the increasing risk of heavy annihilation of infrastructure, especially from the increasingly strong hurricanes, and Helene/Milton showed me that it is all too painful to have been right 😩😭🥲🙃
Water scarcity. Not because of climate change.
Because of economic, infrastructure problems
Earthquakes
Wildfires.
This is kind of a man made disaster specific to the US, but nursing shortage. With boomers retiring and then becoming increasingly sick, current nurse numbers don’t look great. Most of the numbers I’ve forgotten as I wrote a paper on it in nursing school, but I can’t imagine it looks any better now.
It doesn't. The worst part of the nursing crisis is that the nurses that are available will end up overworked to the point of burnout. Then, those burnt-out nurses will leave the jobs, thus worsening the crisis. And when nurses quit, it's a BIG THING. Nurses KNOW how important they are to the healthcare system. Doctors only see a patient for ~15 min. Nurses are the people doing ALL THE WORK. Also, nurses are the backstop on doctor errors with treating patients
Earthquakes are rare in Boston, but if one similar to the Cape Ann earthquake in 1755 were to occur today on a much more populated North Shore of Boston,
the damage could be catastrophic for that area. That quake was quite possibly related to the horrible earthquake a few weeks earlier in Portugal, straight across the Atlantic. If another big one hits there, New England could be next!
All of the East Coast is potential trouble. The Appalachians did not form from nothing, they're still being shoved west and somewhere has got to give way.
Most of these disasters listed here are simply the result of too many humans on earth. Any one of these disasters, then, will hopefully correct that problem. Losing about 7 billion people on earth is no disaster. So maybe none of these is actually a disaster at all.
For the planet, no. For the human race, not really. For individual people, yes. Unfortunately technology just pushes Malthus further down the line, gathering momentum.
Load More Replies...Flood basalt. Any day now, Iceland could transition from being a mild nuisance to vomiting so much basalt that the entirety of Earth's atmosphere becomes unbreathable. Everything that breathes, dies.
Most of these disasters listed here are simply the result of too many humans on earth. Any one of these disasters, then, will hopefully correct that problem. Losing about 7 billion people on earth is no disaster. So maybe none of these is actually a disaster at all.
For the planet, no. For the human race, not really. For individual people, yes. Unfortunately technology just pushes Malthus further down the line, gathering momentum.
Load More Replies...Flood basalt. Any day now, Iceland could transition from being a mild nuisance to vomiting so much basalt that the entirety of Earth's atmosphere becomes unbreathable. Everything that breathes, dies.

 Dark Mode
Dark Mode 

 No fees, cancel anytime
No fees, cancel anytime 















































